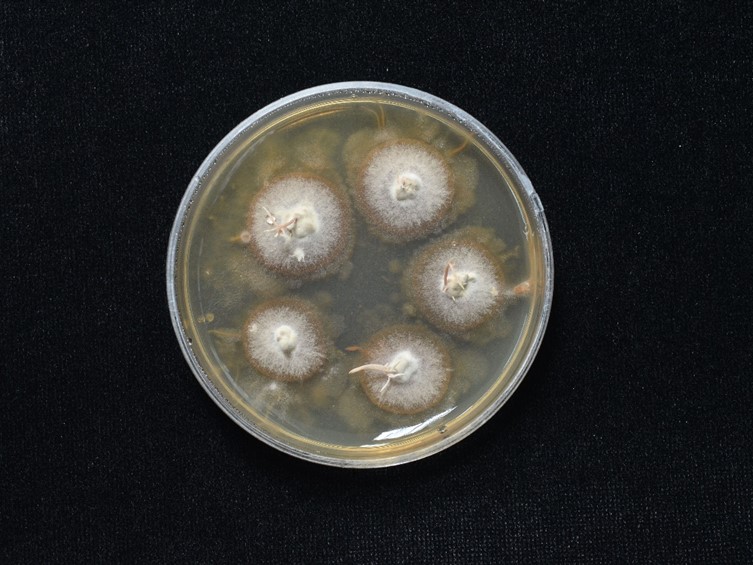

Holotype:
THAILAND, Ratchaburi Province, Chaloem Phrakiat Thai Prachan National Park, 26 May 2011, K. Tasanathai, P. Srikitikulchai, A. Khonsanit, W. Noisripoom, holotype BBH 30544, ex-type living culture BCC 48033.
Habitat:
Buried in soil.
Host:
On Coleoptera.
Description:
 Stromata solitary or in pairs, cylindrical, gradually tapering toward the apex, strong orange yellow to moderate yellow, up to 25 mm long. Stipes cylindrical, smooth, light orange yellow, 0.5–1 mm wide. Rhizoids flexuous, 1–2 cm long buried under the ground, arising from head of Elateridae larvae (Coleoptera).
Stromata solitary or in pairs, cylindrical, gradually tapering toward the apex, strong orange yellow to moderate yellow, up to 25 mm long. Stipes cylindrical, smooth, light orange yellow, 0.5–1 mm wide. Rhizoids flexuous, 1–2 cm long buried under the ground, arising from head of Elateridae larvae (Coleoptera).  Fertile parts distinctly subterminal with asexual morph at apex. Ascomata subterminal, strong orange yellow, crowded
Fertile parts distinctly subterminal with asexual morph at apex. Ascomata subterminal, strong orange yellow, crowded  perithecia, 2–6 mm long, 1.5–2 mm wide. Perithecia completely immersed, pyriform, 220–530 × 110–280 μm.
perithecia, 2–6 mm long, 1.5–2 mm wide. Perithecia completely immersed, pyriform, 220–530 × 110–280 μm. 
 Asci cylindrical, 153–225 × 5–10 μm with asci caps, 1.5–2.5 × 3–4 μm.
Asci cylindrical, 153–225 × 5–10 μm with asci caps, 1.5–2.5 × 3–4 μm.  Ascospores cylindrical, breaking into truncate partspores, 3–9 × 1.5–2 μm. Asexual morph:
Ascospores cylindrical, breaking into truncate partspores, 3–9 × 1.5–2 μm. Asexual morph:  Conidiogenous cells monophialidic or polyphialidic, cylindrical basal portion, 8–19 × 3–4 μm with a distinct, filiform, long neck up to 20 μm.
Conidiogenous cells monophialidic or polyphialidic, cylindrical basal portion, 8–19 × 3–4 μm with a distinct, filiform, long neck up to 20 μm.  Conidia hyaline, smooth-walled, globose to subglobose, 2–3.5 × 2–3 μm diam, a mucous sheath observed in mature conidia.
Conidia hyaline, smooth-walled, globose to subglobose, 2–3.5 × 2–3 μm diam, a mucous sheath observed in mature conidia.
Culture characteristics:
Colonies on PDA attaining a diam of 15–20 mm in 30 d, white, colonies reverse moderate reddish brown. Synnemata white to dark pink, in the middle of colonies.
Colonies on PDA attaining a diam of 15–20 mm in 30 d, white, colonies reverse moderate reddish brown. Synnemata white to dark pink, in the middle of colonies.  Conidiogenous cells monophialidic or polyphialidic, arising from either the lateral or terminal regions of the hyphae, cylindrical basal portion, 10–44 × 2–4 μm with a distinct, filiform, long neck up to 28 μm.
Conidiogenous cells monophialidic or polyphialidic, arising from either the lateral or terminal regions of the hyphae, cylindrical basal portion, 10–44 × 2–4 μm with a distinct, filiform, long neck up to 28 μm.  Conidia hyaline, smooth-walled, globose to subglobose, 1.5–4 × 1.5–3.5 μm with a mucous sheath.
Conidia hyaline, smooth-walled, globose to subglobose, 1.5–4 × 1.5–3.5 μm with a mucous sheath.
Reference:
Mongkolsamrit S, Noisripoom W, Tasanathai K, et al. (2024). Uncovering cryptic species diversity of Ophiocordyceps (Ophiocordycipitaceae) associated with Coleoptera from Thailand. Fungal Systematics and Evolution14: 223–250.
DOI: https://doi:10.3114/fuse.2024.14.15Species |
Strain |
Compound |
Pubchem CID |
Biological activity |
Reference |
|---|
|
Strain |
|---|